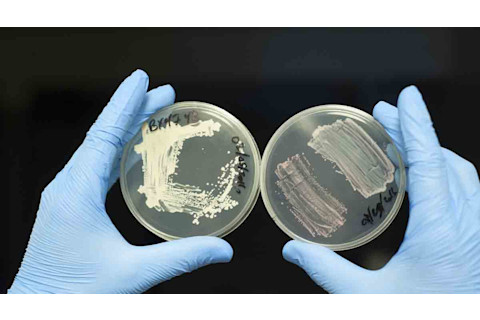

乔治·卡奇亚尼斯敲响桌上的铃铛,示意课堂安静。二十六名青少年生物技术人员围坐在三张桌子旁。卡奇亚尼斯在旧金山亚伯拉罕·林肯高中为一群精选的初三和高三学生教授生物技术原理——他称之为“欢迎来到研究生院”。
他的22号教室不仅仅是教室,还是一个功能齐全的实验室。其设备通过拨款和捐赠获得,可以处理DNA测序和蛋白质分析等任务。但今天的课程是关于一种新技术的,一种可以改变任何生物体基因——以及潜在地,其后代基因——的方法。它被称为Crispr-Cas9。

乔治·卡奇亚尼斯与他在旧金山亚伯拉罕·林肯高中的生物技术学生们一起开怀大笑。 | Ernie Mastroianni/发现杂志
Crispr-Cas9是一种精巧的工具,名字却不那么优雅,但它让生物技术界为之振奋。分子生物学家、生物医学研究人员以及生命科学领域的领导者都采用了它。与早期修改细菌、植物、实验鼠和人类细胞基因组的方法相比,Crispr-Cas9基因编辑方法快速、精确且廉价,比其他方法好了一个数量级。更重要的是,它足够简单,高中生也能使用。
Crispr-Cas9诞生才刚刚四年,由加州大学伯克利分校的科学家詹妮弗·杜德纳(Jennifer Doudna)率先开发。杜德纳和她的合作者,来自柏林马克斯·普朗克感染生物学研究所的埃曼纽尔·沙尔庞捷(Emmanuelle Charpentier),当时正在研究细菌如何识别和切断入侵病毒以消除威胁。两人意识到,细菌的防御系统可以为科学家所用。他们设计了一种杜德纳称之为“可编程DNA切割酶”的东西。
该系统主要由两部分组成。Crispr 是可编程部分,是细菌识别和靶向病毒引入的外国基因的机制。在细菌中,Crispr 会产生一种名为引导RNA的RNA。引导RNA——可以将其视为导航员——将Cas9酶递送到外来基因组的正确位置,Cas9 随后在此处进行破坏性切割。杜德纳的团队通过合成他们自己的引导RNA版本来重新编程这种自然操作。合成引导RNA和Cas9共同形成一个能够编辑任何基因的复合体。
然而,早在Crispr-Cas9突破之前,湾区就已是生物技术蓬勃发展的城镇。从时髦的旧金山东部到博学的伯克利和勤奋的奥克兰,再向南延伸到硅谷的苹果、脸书和谷歌的领地,湾区拥有美国最大的生物技术综合体,新企业几乎每天都在涌现。这个经济部门创造了近1000亿美元的产值和超过10万个就业岗位。卡奇亚尼斯自豪地说,他以前的学生在1600家公司中的一家或多家工作。该地区唯一的竞争对手是马萨诸塞州的剑桥,那里哈佛大学和麻省理工学院是生物技术和生命科学领域的创新者。
Crispr-Cas9的狂热采用重新调整了湾区各级科学领域的职业生涯,并赋予了新用户权力:伯克利大学的远见者、东湾的企业家、硅谷的企业人士、DIY社区,是的,还有青少年们。
学生实习生
Crispr-Cas9问世后不久,卡奇亚尼斯就将其演示纳入了他的课程:他的林肯高中学生们改造大肠杆菌,这种细菌相对容易操作。卡奇亚尼斯获得了经过基因工程改造表达红色荧光蛋白(简称RFP)的细菌。学生们Crispr-Cas9项目的任务是关闭RFP基因,使细菌恢复其正常颜色。
我到访那天,班上学生听同学瓦妮莎·阿雷奥拉(Vanessa Arreola)分享她在旧金山一家私人研究基金会格莱斯顿研究所(Gladstone Institutes)暑期实习期间学到的技术。作为一名实验室技术员,她没有亲手制造Crispr-Cas9复合体,但她确实使用了它。
黑发,娇小的阿雷奥拉,指甲涂着青绿色指甲油,她滔滔不绝地讲述着事实,将一个夏天的学习压缩在20分钟内。“Crispr-Cas9的作用很容易理解,”她开始说,“但要理解它如何做到这一点就很难了。”
她描绘了该系统在自然状态下的样子,正如科学家们在细菌和相关生物(称为古生菌)中观察到的那样。Crispr 代表“成簇的、规律间隔的短回文重复序列”。这些是细菌在其免疫反应中吸收的外源DNA片段,可以一次又一次地被触发。Arreola 展示了 Crispr DNA 如何为 Cas9 酶生成引导RNA。“处理RNA很难,”她说,卡奇亚亚尼斯插话说:“你知道我怎么说吗——RNA 是如此不稳定,如果你给它一个不友好的眼神,它就会散架。”
一只手举了起来。“这和基因剪接一样吗?”“是的,”阿雷奥拉回答道。看来她的同学们都明白了。
接下来,她谈到了她暑期项目的重点:编辑心脏干细胞,以了解更多关于一种先天性心脏病的信息。阿雷奥拉在格莱斯顿研究所的导师、研究员凯西·吉福德(Casey Gifford)要求我不要说出这种疾病或她的实验室正在研究的基因名称——她不想引起任何潜在竞争对手的注意。“有了 Crispr-Cas9,一切都变得如此简单,”吉福德说,“我已经领先一步了。但其他人也可以很快做到。”
Crispr-Cas9的工作原理
1. 细菌DNA具有不寻常的重复序列,这些序列由间隔区——短的非编码片段,有时不恰当地称为“垃圾DNA”——分隔开。这些重复序列已被命名为CRISPR(或Crispr),意为“成簇的、规律间隔的短回文重复序列”。每个Crispr序列附近都有各种Cas(Crispr相关)酶的基因,包括Cas9。
2. 当面临外部威胁,例如入侵病毒时,Cas酶会生成一种“通缉令”:它们会剪掉入侵病毒DNA的片段并将其塞入间隔区,在那里它们可以作为RNA引导物来识别未来的入侵者。研究人员利用细菌的这种天然防御机制作为Crispr-Cas9基因编辑系统的基础,创建合成引导物来寻找研究人员选择的特定DNA碱基串。您可以将该系统分为两部分:引导Crispr和切割Cas9酶。
3. 当引导RNA找到其目标DNA时,它会附着上去,然后Cas9会切断DNA双螺旋的两条链。切断的DNA随后要么保持原样,使其沉默,要么通过使用基因编辑器插入一个新的、功能性的片段来修复。
远见者
在杜德纳-沙尔庞捷于2012年发表宣布Crispr-Cas9的论文后,杜德纳和她在加州大学伯克利分校的同事们开始收到其他研究人员的请求,寻求使用该技术的帮助。请求变成了“洪水”,雅各布·科恩(Jacob Corn)说,他是一位生物化学家,曾在南旧金山一家主要生物技术公司Genentech工作。
2014年,杜德纳请科恩来管理这股浪潮,同时也要积极主动:完善这项新技术,并通过大学新成立的一个研究所推广它。科恩领导着创新基因组学倡议(IGI)的旗舰实验室,该倡议是湾区10名研究人员组成的联盟。他们分享想法和实验室材料,举行会议,并为该地区以外的研究人员开设课程。
Crispr-Cas9 的热潮重现了一代人前基因疗法所带来的希望。基因疗法曾被认为将利用人类基因组计划的成果,即人类DNA的序列记录,并利用这些信息来纠正数十种疾病。但这并没有发生,部分原因是将健康基因副本传递到不健康细胞的方法过于粗糙,部分原因是大多数常见人类疾病没有明确的遗传靶点。这并没有让加州大学旧金山分校IGI研究员亚历克斯·马森(Alex Marson)感到困惑。“在数十年的绘制基因组图谱和获取其详细信息之后,”他说,“现在是时候进入并改变序列,看看功能是如何改变的了。”
这种新方法对马森的事业大有裨益。当Crispr-Cas9出现时,“我全身心投入其中。”
科恩在自己的实验室里也用 Crispr-Cas9 进行实验,同样充满热情。“这是一个特殊的时代。Crispr-Cas9 周围有很多‘狂飙突进’,”他说。“它能做什么?不能做什么?人们正在意识到它将无处不在。这种爆炸式增长来自于积压已久的实验瓶颈。”
“很难跟上。现在每天都有多达三篇Crispr-Cas9论文发表 [在期刊上]——也就是说每周21篇。这可能还是低估了;一些研究人员还没有发表,因为他们被其他人抢先了。”
“是的,人们从90年代就开始进行基因组编辑了。当时有工具可以做到这一点,但不是每个人都有,”科恩补充道,指的是其他可以切割特定基因的蛋白质,但这些蛋白质成本更高,需要更多时间。
Crispr-Cas9 已经拉平了竞争环境,Corn 说。拥有大型实验室和雄厚资金的研究人员可以负担得起早期的基因编辑工具,但 Crispr-Cas9 几乎没有准入门槛。正如 Corn 在一篇博文中所阐述的:“这把一项排他性的实践,即有问题的人无法获得答案,变成了一项包容性的实践,即许多问题导致许多答案。我经常称之为基因编辑的‘民主化’。”
工程师
伯克利的IGI实验室里,一排排穿着白大褂的年轻人埋头工作,有些背对着彼此,有些则头碰头地商量着。科恩带我去了马克·德威特(Mark DeWitt)这位博士后研究员的工作台。德威特于2014年受聘,负责IGI团队的任务是治愈小鼠的镰状细胞病——他的团队是众多正在研究这一想法的团队之一。
德威特的实验旨在证明Crispr-Cas9可以帮助数十万人,其中大多数在非洲和印度,他们携带有两个有缺陷的HBB基因拷贝。这个基因制造血红蛋白,即红细胞的物质。在疾病状态下,血细胞呈镰刀状而非圆形,导致剧烈疼痛和最终的器官损伤。计划是从患者的骨髓中提取造血干细胞,并纠正尽可能多的突变基因拷贝。理论上,当干细胞返回患者体内时,它们将产生足够的正常血红蛋白来对抗症状,即使不能完全消除疾病。
德威特解释说,Crispr-Cas9既用于将有害突变插入小鼠体内,也用于通过植入正常版本的HBB(称为野生型)来逆转缺陷。在这两种情况下,Cas9的切割都会在基因位点触发自动修复过程。在修复生化断裂时,DNA会整合研究人员提供的HBB变体:导致疾病的突变形式,然后是治愈疾病的正常形式。
德威特说,组装 Crispr-Cas9 套件并非难事。独立工程化的纯化 Cas9 酶和引导 RNA 溶液在试管中混合并结合成蛋白质复合体。他将第三种成分称为模板或供体 DNA:“它是编码您想要进行的编辑的 DNA,在本例中是野生型 HBB。”
德威特将Crispr-Cas9复合体和DNA替换部分添加到含有突变干细胞的溶液中。通过电穿孔——用科恩的话说,“我们通过电流在细胞上打孔”——他将复合体和替换部分注入细胞的保护膜中。
德威特将一个微波炉大小的塑料托盘放在电穿孔装置的罩子下,托盘上有16个指套大小的孔,里面装满了培养物。在比加热一顿冷冻餐更短的时间内,一部分细胞在无形中被转化,一条DNA链被替换成另一条。
第一个实现镰状细胞和地中海贫血(一种相关的血液疾病)基因重写的小组将获得巨大成功。最近,科恩、德威特和IGI团队的其他成员发表了一篇关于他们在小鼠身上取得的喜人结果的论文。在进行人体试验之前,他们需要研究所有“脱靶”效应的实例:在Crispr出现之前的几年,用于基因治疗试验中递送DNA的病毒偶尔会损害整个系统,导致癌症。问题在于研究人员无法将DNA包定向到染色体上的正确位置。
探矿者
杜德纳在2012年初,即她与沙尔庞捷的论文发表之际,在伯克利创立了Caribou Biosciences。这家公司是她在Crispr-Cas9领域的商业赌注,并在加州大学伯克利分校律师的支持下,她对麻省理工学院研究员张锋发起了专利诉讼,张锋声称他也在同一时间发明了这项技术,并拥有其商业化的权利。Caribou旨在将Crispr-Cas9带入生命科学的所有领域,从农业和工业生物技术到医学和分子生物学。公司的口号冷静而自豪:“以任何方式,在任何位点,对任何基因组进行工程改造。”
Caribou 的一层办公室和实验室位于伯克利奥克兰一侧高速公路附近一个略显粗糙的社区。我在那里见到了首席科学官安迪·梅(Andy May)。43岁的梅是公司里年龄较大的员工之一,公司目前有二十多人,并且还在不断增加。
“你们候诊室的牌子为什么写着‘面包店’?”我问道。
“因为这里以前是一家Twinkie工厂,”他说。
据梅介绍,Crispr-Cas9是分子生物学领域自20世纪80年代PCR(聚合酶链式反应)技术发展以来最重大的突破。得益于PCR,科学家可以大量扩增DNA,从而“读取”各种生物体及其所有变异的基因序列。“我们已经拥有读取基因信息的能力,但我们还没有将其写回细胞的能力,”梅说,“现在我们可以将其写回并编辑。我们已经完成了这个循环。”
Caribou公司30岁的首席执行官兼联合创始人蕾切尔·豪尔维茨(Rachel Haurwitz)也加入了我们的会议室,她在杜德纳门下获得了分子与细胞生物学博士学位。Caribou已经从杜邦和诺华等企业巨头那里获得了Crispr-Cas9项目的资金,尽管豪尔维茨不愿告诉我具体是什么项目。“我们是一家平台技术公司,”她说,“我们制造Cas9蛋白,我们拥有工具和生物信息学,可以分析大量的实验。我们正在努力理解细节,以获得理解并解释其安全性。”
豪尔维茨磨练了她的销售话术。“为了真正造福人类,”她说,“你必须将其商业化。投资者很兴奋,但他们明白(回报)可能要十年后才能到来。我们一直在边飞边造飞机。如果你赢了,那将是一场巨大的胜利。”
我从Caribou公司南下,穿过繁忙的交通,来到位于旧金山半岛底部的圣克拉拉。这里是安捷伦科技公司的总部,一家年收入40亿美元,为生物技术产业及其他科学研究提供全球服务的供应商。我遇到的两位员工——安捷伦研究实验室主任斯蒂芬·拉德曼(Stephen Laderman)和负责Crispr-Cas9产品开发的劳拉凯·布鲁恩(Laurakay Bruhn)——比梅和豪尔维茨年长一代。他们的会议室比Caribou的大一倍,椅子也更豪华。他们毫不怀疑他们所称的“基因编辑爆炸”的重要性,但他们尚不确定Crispr-Cas9对他们公司的价值。
“这是一场未来的博弈,”拉德曼狡猾地说。“我们不仅在制造工具,(而且还在)进行测量,以确定工具的作用。”他所说的测量,指的是实验的验证,这是研究人员有时会忽视的部分。购买Crispr-Cas9套装,一个很酷的新工具用于你的项目,是一回事;确保它确实有效,又是另一回事。例如,安捷伦可能会帮助一家制药公司确定一种新基因疗法产品的任何脱靶效应。
Caribou 的 May 和 Haurwitz 也提供相同的服务,但他们暗示自己会做得更好。他们将 Agilent 称为“一家硬件公司,销售镐和铲子”。“我们有时确实将自己称为销售镐和铲子的公司,”Laderman 承认。Bruhn 补充道:“我们非常擅长制造 RNA。(客户)不想自己制造镐。他们想找到黄金。”
巫师们
Crispr-Cas9的实验重点和推定益处主要集中在人类及其生物医学问题上,伴随着一些对永久性增强我们基因的紧张猜测。去年中国科学家对人类胚胎进行的测试促使召开了一次国际会议,以劝阻这类研究。
事实是,任何生物的DNA都可以被永久改变——这正在加州大学伯克利分校的尼帕姆·帕特尔(Nipam Patel)实验室中发生。作为一名发育生物学家,帕特尔编辑“非传统模型物种”的基因组,包括蝴蝶和甲壳类动物。通过在胚胎中关闭基因,帕特尔和他的团队对发育途径获得了深刻的见解,例如蝴蝶如何长出独特的翅膀图案。
Crispr-Cas9使他的实验室探索速度加快了10倍。“节省的成本是巨大的,”帕特尔说,“敲除一个基因只需75美元。这太疯狂了,与我们以前支付的相比。”帕特尔以前使用一种名为RNA干扰(RNAi)的技术,他说这种技术成本是现在的10倍。“而且只有一些效果很好,”他说,“我们用RNAi花了两年时间改造了三个基因,而用Crispr只用了几个月就改造了七个基因。Cas9酶高效且稳定。动物从一开始就发生了变化。”
帕特尔感兴趣的基因决定了身体的结构,控制着一个新生的生物如何以及何时形成其肢体、口器、触角等。这类基因的一个子集,被称为Hox基因,在整个动物界中都有发现,人类和果蝇也不例外。帕特尔专注于一种微小的甲壳动物——夏威夷沙跳虫(Parhyale hawaiensis)的Hox基因。当Crispr-Cas9敲除胚胎沙跳虫的Hox基因时,会发生奇怪的事情,比如游泳足的位置长出了钳形足,或者口部长出了触角。相反的方法是“敲入”,将外源DNA插入Hox基因中,例如,导致在荧光灯下会发出绿光的钳子。
我参观时,两位生物学家艾琳·贾维斯(Erin Jarvis)和阿尔诺·马丁(Arnaud Martin)正在从培养皿中游泳的雌性海跳蚤身上采集受精卵。接下来,研究人员在细胞分裂之前将Crispr-Cas9包注入卵中,以尽可能多地改造发育中的甲壳类动物的细胞。操作在显微镜下进行,使用几乎看不见的针和探针;研究人员必须拥有极其稳定的双手。“注射日不能喝咖啡,”贾维斯打趣道。
当被问及 Crispr-Cas9 所赋予他们的权力是否令他们犹豫时,Jarvis 提出了标准的理由:“我们正在努力理解遗传过程。这有助于基础科学,因此我们可以更多地了解我们自己。”
马丁说:“这是修改自然的工具。但我们什么时候才能停止改造自然呢?这有点像弗兰肯斯坦。”
讨论转向了基因驱动,目前这只是一个概念。突变可以植入到一定数量的蚊子、啮齿动物或其他害虫体内,而这种突变将永久地传播到整个种群中,无论是好是坏。生物学家会做正确的事情吗?而他们认为正确的事情——会按计划进行吗?
“我希望我是一个好巫师,”马丁说,“但我害怕魔法。”
生物黑客
如果这么容易,为什么只写Crispr-Cas9呢?我想亲手试试,你知道的,改造一些东西。
我求助于乔赛亚·扎伊纳(Josiah Zayner),一个35岁的反叛者,拥有博士学位。对扎伊纳来说,“生物黑客”一词将DIY作为一种政治主张。
在他位于旧金山机场附近郊区公寓的厨房里,街上的交通噪音隐约传来。我们戴上了一次性手套——“虽然我们并不真的需要它们,”他说——他递给我一个试管。“你以前用过移液管吗?”
移液管就像一个大的医用滴管,可以精确地分配液体。我的第一个任务是把氯化钙溶液注入试管。“要进行转化,你必须欺骗细菌,”他说,“你加入一些氯化钙来中和DNA的电荷,让它渗透细胞膜。”
我用拇指按压柱塞。接下来呢?
“现在我们需要一些细菌进去。它们一直待在我的冰箱里。我们刮一些下来吧。”
生物黑客运动指的是非科学家、准科学家以及大量兼职的专业科学家,他们正在用大大小小的“为什么不呢?”项目亲自动手进行分子生物学研究。想想看,在荧光灯下表达不同颜色的酵母培养物,或者不是由奶牛而是由植入牛奶蛋白基因的微生物制成的奶酪。这只是伯克利生物实验室、奥克兰反文化实验室或桑尼维尔生物好奇实验室举办的聚会中涌现的两个项目。反文化实验室网站上写道:“我们的目标是揭开这项技术的神秘面纱并使其民主化,将工具交到那些想要学习的人手中。”
所以扎伊纳几乎不收费地投入时间,至少今晚,他会赋能像我这样的人。直到最近,他的白天都在美国宇航局度过;他的任务是开发能够降解长途太空任务中塑料的细菌。他不太喜欢这份工作。他曾考虑加入一家领先的生物技术公司,但这需要改变他的外表:双色头发和两耳都戴着耳钉。目前,他正努力成为一名“独立科学家”。
他拿起两个试管,开始旋转。细菌在里面。模板DNA在里面。Cas9酶在里面,引导RNA也在里面。一个质粒,一种简单的DNA递送载体,将把抗生素抗性基因转移到细菌细胞中,启动Crispr-Cas9系统。实验的目的是突变细菌中的一个基因,使其具有抗生素抗性,然后通过用抗生素处理培养物来证明这一点。我们大约一天后才能知道结果。(剧透:成功了。)
扎伊纳对民主化的看法比 IGI 的愿景更强硬。当然,Crispr-Cas9 的商品化是好事,因为大部分制造工作由工业界接管。马萨诸塞州剑桥市的一家公司 Addgene 报告称,“自 2012 年以来,它已向全球 15,000 名科学家分发了约 50,000 个 Crispr-Cas9 质粒。”Patel 和 Corn 可能对成本下降感到高兴,但扎伊纳认为从 Addgene 购买 Crispr-Cas9 质粒需要 65 美元太多了。
“研究人员拥有数百万,所以公司抬高了价格,”当我们走进客厅时,他抱怨道。“我为什么要为获取公共资助的研究付费?我认为科学需要民主化。公众没有必要的Crispr-Cas9 DIY协议。最好用的Cas9序列是什么?你去哪里获得这些化学品?”
“你拥有这种潜在的绝佳疗法。如果在黑客空间里,有1000个人在研究Cas9呢?人们会进来贡献东西。你必须教育他们,然后你就可以解放他们。”
11月,扎伊纳发起了一项Indiegogo众筹活动,为Crispr-Cas9套件的生产筹集资金。在线宣传语是“DIY Crispr套件,通过实践学习现代科学”。目标是在一个月内通过众筹筹集1万美元。他筹到了6.5万美元。为了购买组件,他与海外供应商和独立制造商进行了谈判。不是Addgene或Agilent?不可能。扎伊纳说:“我的套件便宜得离谱。”截至发稿时,他正准备发货。
它切片!它剪接!
Crispr-Cas9“作案”现场
制造变异沙跳虫:沙跳虫胚胎(顶部),半毫米大小,由加州大学伯克利分校的研究生艾琳·贾维斯(Erin Jarvis)排好并准备注射。如果没有干预,胚胎将发育成正常的甲壳类动物。但细如发丝的针(右)注入了微量的Cas9蛋白和引导RNA——仅50万亿分之一升。在几个小时内,它将产生永久改变沙跳虫DNA的突变。例如,在一个实验中,研究人员使变异沙跳虫长出了向前行走的腿(右下),而不是跳跃腿,这在野生沙跳虫中可见(左下,为识别目的着色)。两者都是扫描电子显微镜图像。
Ernie Mastroianni/发现杂志
粉色酵母:常见的酿酒酵母酿酒酵母(Saccharomyces cerevisiae)在其自然状态下呈奶白色(左下)。自称生物黑客的 Josiah Zayner 用 Crispr-Cas9 对其进行操作后,它呈现出明显的粉红色(右下)。基因编辑器切割了酵母的 ADE2 基因,并使用供体 DNA 插入了几个额外的核苷酸。“粉色是这种突变的众所周知的结果,”他说。















